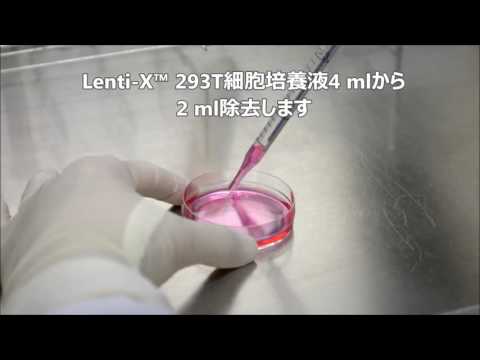
IUCN分類における絶滅の危険性を示す図。

導入
| プラタイプリス・ツベリフェラ | ||
|---|---|---|
 | ||
| 分類 | ||
| 治世 | 動物界 | |
| 支店 | 脊索動物 | |
| サブエンブレム。 | 脊椎動物 | |
| クラス | 両生類 | |
| サブクラス | リサンフィア | |
| スーパーオーダー | サリエンシア | |
| 注文 | アヌラ | |
| 亜目 | 新生気管症 | |
| 家族 | ミクロギリ科 | |
| サブファミリー | コフィリナ科 | |
| 性別 | プラティペリス | |
| 二項名 | ||
| プラタイプリス・ツベリフェラ (メシュエン、1920) | ||
| 同義語 | ||
| ||
| IUCNの保全状況: LC :小さな懸念 | ||
Platypelis tuberifera は、Microhylidae 科の両生類の種です。
分布

Platypelis tuberiferaの分布域。
この種はマダガスカルの固有種です。アンツィラナナ県のマノンガリボ山塊の南とアンドリンギトラ山塊の間の標高400~ 1,200メートルの間に見られます。
オリジナル出版物
- Methuen、1920「1919」:トランスバール産の新しいヘビ、ゼノカラムス属の新しい診断と鍵、およびマダガスカル産のいくつかのバトラキアの説明。ロンドン動物学会論文集、vol. 1919年、 p. 349-355 (全文)。
説明
Platypelis tuberifera の大きさは 30 ~ 40 mmです。背中は茶色から黄色まで変化し、通常は明るい正中線があり、時には暗いまたは明るい斑点があります。お腹は白っぽいです。背中の皮膚は滑らかです。男性には単一の声嚢があります。